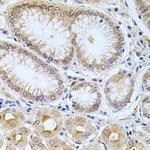
Carboxypeptidase M Antibody in Immunohistochemistry (Paraffin) (IHC (P))

Search
Invitrogen
Carboxypeptidase M Polyclonal Antibody
{{$productOrderCtrl.translations['antibody.pdp.commerceCard.promotion.promotions']}}
{{$productOrderCtrl.translations['antibody.pdp.commerceCard.promotion.viewpromo']}}
{{$productOrderCtrl.translations['antibody.pdp.commerceCard.promotion.promocode']}}: {{promo.promoCode}} {{promo.promoTitle}} {{promo.promoDescription}}. {{$productOrderCtrl.translations['antibody.pdp.commerceCard.promotion.learnmore']}}
图: 1 / 4
Carboxypeptidase M Antibody (PA5-93064) in IHC (P)

Please note: We are reviewing Western blot images included in the antibody testing data in our catalog, including those provided by third parties. Unless expressly labeled or annotated as “raw-unedited”, Western blot images included in the antibody testing data in our catalog may have been edited, optimized or otherwise adjusted for presentation.
产品信息
PA5-93064
种属反应
宿主/亚型
分类
类型
抗原
偶联物
形式
浓度
规格
纯化类型
保存液
内含物
保存条件
运输条件
RRID
产品详细信息
Immunogen sequence: VQATGALYSR SLTPDDDVFQ YLAHTYASRN PNMKKGDECK NKMNFPNGVT NGYSWYPLQG GMQDYNYIWA QCFEITLELS CCKYPREEKL PSFWNNNKAS LIEYIKQVHL GVKGQVFDQN GNPLPNVIVE VQDRKHICPY RTNKYGEYYL LLLPGSYIIN VTVPGHDPHI TKVIIPEKSQ NFSALKKDIL LPFQGQLDSI PVSNPSCPMI PLYRNLPDHS AATKPSLFLF LVSLLHIFFK; Positive Samples: HeLa; Cellular Location: Cell membrane, GPI-anchor, Lipid-anchor
靶标信息
Specifically removes C-terminal basic residues (Arg or Lys) from peptides and proteins. It is believed to play important roles in the control of peptide hormone and growth factor activity at the cell surface, and in the membrane-localized degradation of extracellular proteins.
仅用于科研。不用于诊断过程。未经明确授权不得转售。
篇参考文献 (0)
生物信息学
蛋白别名: Carboxypeptidase M; CPM; renal carboxypeptidase; unnamed protein product; urinary carboxypeptidase B
基因别名: CPM
Entrez Gene ID: (Human) 1368, (Rat) 314855




